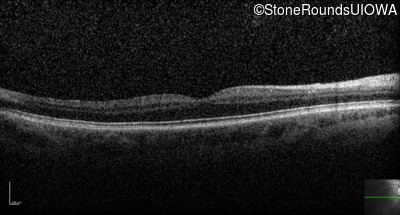
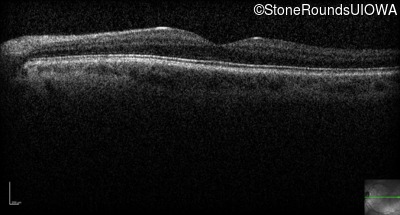

Case
SR249
Student Mode
Congenital Stationary Synaptic Dysfunction (IA2g)
Male
Male
Hidden
SR249
Student Mode
Congenital Stationary Synaptic Dysfunction (IA2g)
Male
Male
History
This 45 year old man had nystagmus in the first year of life.
| Color Vision: | Normal color naming |
|---|---|
| Refraction OD: | -3.00 +2.50 x 70 |
| Refraction OS: | -2.25 +2.00 x 120 |
Teaching Points
The clinical features supporting the diagnosis of congenital stationary synaptic dysfunction in this patient include: nystagmus noticed in the first year of life; reduced acuity; normal color naming; a normal fundus appearance; a normal OCT; selective loss of the b-wave on the scotopic bright flash ERG; normally sighted parents; and, a similarly affected maternal grandfather and maternal male cousin.
Diagnosis & molecular findings
| Disease | Gene | Allele 1 variant(s) | Allele 2 variant(s) | Inheritance mode |
|---|---|---|---|---|
| Congenital Stationary Synaptic Dysfunction | CACNA1F | Arg513Stop CGA>TGA | XL |
Gene:
Allele 1:
Arg513Stop CGA>TGA
Allele 2:
Inheritance:
XL